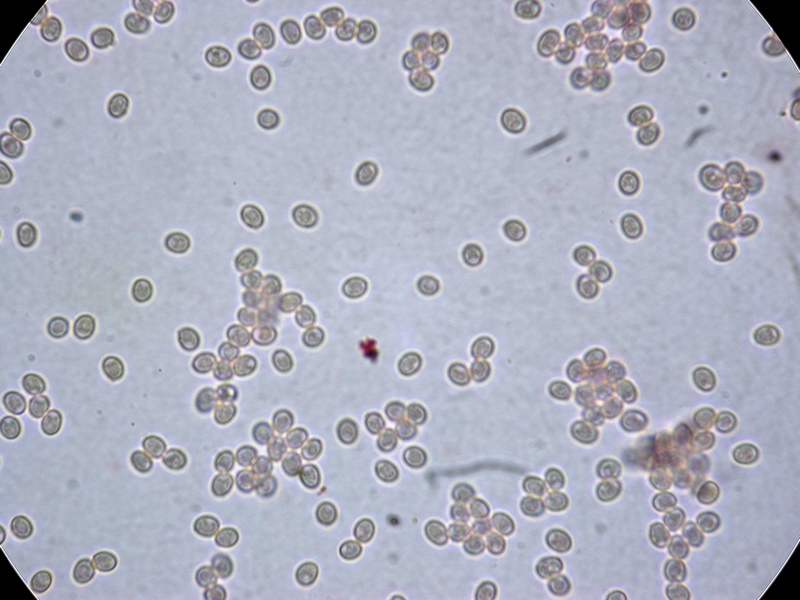
Ennioquiz 1

|
|
|
|
|
Galleria Tassonomica
di
Natura Mediterraneo
|
 ATTENZIONE! Le indicazioni o considerazioni sulla commestibilità o tossicità dei funghi contenute nelle Sezioni del Forum non devono in alcun modo incoraggiare Frequentatori e Utenti al consumo indiscriminato di funghi selvatici. Per tali esigenze la Legge nazionale ha istituito gli Ispettorati Micologici presso le ASL. Allo stato attuale, gli Ispettorati Micologici sono le uniche strutture in Italia in grado di procedere al riconoscimento dei funghi selvatici ed alla relativa attestazione di commestibilità, previa esame gratuito (cernita ispettiva) delle raccolte richiesto dal cittadino. Le finalità del Forum di Micologia, in sintonia con gli scopi di NaturaMediterraneo, riguardano lo studio, l’approfondimento, la valorizzazione e la divulgazione, anche per finalità di tutela, del Regno Funghi. Si declina pertanto qualunque responsabilità, sia penale che civile, derivante dall’inosservanza di questa avvertenza. ATTENZIONE! Le indicazioni o considerazioni sulla commestibilità o tossicità dei funghi contenute nelle Sezioni del Forum non devono in alcun modo incoraggiare Frequentatori e Utenti al consumo indiscriminato di funghi selvatici. Per tali esigenze la Legge nazionale ha istituito gli Ispettorati Micologici presso le ASL. Allo stato attuale, gli Ispettorati Micologici sono le uniche strutture in Italia in grado di procedere al riconoscimento dei funghi selvatici ed alla relativa attestazione di commestibilità, previa esame gratuito (cernita ispettiva) delle raccolte richiesto dal cittadino. Le finalità del Forum di Micologia, in sintonia con gli scopi di NaturaMediterraneo, riguardano lo studio, l’approfondimento, la valorizzazione e la divulgazione, anche per finalità di tutela, del Regno Funghi. Si declina pertanto qualunque responsabilità, sia penale che civile, derivante dall’inosservanza di questa avvertenza.
|
|
| Autore |
 Discussione Discussione  |
|
FOX
Moderatore
    

Città: BAGNO A RIPOLI
Regione: Toscana

21536 Messaggi
Tutti i Forum |
 Inserito il - 14 dicembre 2009 : 18:47:04 Inserito il - 14 dicembre 2009 : 18:47:04


|
Leucopaxillus albissimus
simo
Alto è il prezzo quando si sfida per vanità il mistero della Natura - I. Sheehan |
 |
|
|
win67
Utente Senior
   
Città: bologna
Prov.: Bologna
Regione: Emilia Romagna

661 Messaggi
Micologia |
 Inserito il - 14 dicembre 2009 : 18:52:37 Inserito il - 14 dicembre 2009 : 18:52:37


|
Io arrivo a Lyophyllum ed è già troppo 
Vincenzo |
 |
|
|
gentile
Utente Junior
 
Città: trento
Prov.: Trento
Regione: Trentino - Alto Adige

58 Messaggi
Tutti i Forum |
 Inserito il - 14 dicembre 2009 : 19:44:15 Inserito il - 14 dicembre 2009 : 19:44:15


|
vero ....!!
Leucopaxillus sp.Ci provo... |
 |
|
|
Ernesto Marra
Moderatore
   

Città: Lamezia Terme
Prov.: Catanzaro

2909 Messaggi
Micologia |
 Inserito il - 14 dicembre 2009 : 23:08:10 Inserito il - 14 dicembre 2009 : 23:08:10


|
ok..ok, ho capito si deve essere proprio precisissimi  
testardamente insisto...
Lyophyllum hypoxanthum
già Calocybe hypoxantha |
Modificato da - Ernesto Marra in data 14 dicembre 2009 23:15:43 |
 |
|
|
Ernesto Marra
Moderatore
   

Città: Lamezia Terme
Prov.: Catanzaro

2909 Messaggi
Micologia |
 Inserito il - 14 dicembre 2009 : 23:12:50 Inserito il - 14 dicembre 2009 : 23:12:50


|
Guardando bene nelle foto si vedono anche gli aghi di Cuprexus che è il suo habitat 

Ernesto |
Modificato da - Ernesto Marra in data 14 dicembre 2009 23:20:42 |
 |
|
|
FOX
Moderatore
    

Città: BAGNO A RIPOLI
Regione: Toscana

21536 Messaggi
Tutti i Forum |
 Inserito il - 14 dicembre 2009 : 23:20:37 Inserito il - 14 dicembre 2009 : 23:20:37


|
E dove Ennio ha trovato il cipresso ?
simo
Alto è il prezzo quando si sfida per vanità il mistero della Natura - I. Sheehan |
 |
|
|
Ernesto Marra
Moderatore
   

Città: Lamezia Terme
Prov.: Catanzaro

2909 Messaggi
Micologia |
 Inserito il - 14 dicembre 2009 : 23:34:38 Inserito il - 14 dicembre 2009 : 23:34:38


|
Non ne ho idea... però questo particolare della foto ..
Cuprexus est 
Immagine:

20,34 KB
|
 |
|
|
Ennio Carassai
Moderatore
   
Città: Macerata
Prov.: Macerata
Regione: Marche

1851 Messaggi
Micologia |
 Inserito il - 15 dicembre 2009 : 00:48:24 Inserito il - 15 dicembre 2009 : 00:48:24


|
bravo Ernesto (Giget), complimenti!,si tratta proprio di Lyophyllum hypoxanthum Joss. & Riousset 1974.
Questa specie può raggiungere anche 25 cm di diametro pileico e carne molto spessa e soda, lamelle di un bellissimo giallo uovo brillante, cresce seminterrata tra lo strato umifero degli aghi di cupressus sempervirens in tardo autunno-primo inverno.
Specie vicina a L. buxeum ma che al contrario di questi, non ha carne annerente o al più solo leggermente ingrigente.
Adesso meritate qualche immagine relativa, grazie a chi ha partecipato,
Ennio.
Immagine:

192,6 KB |
 |
|
|
Ennio Carassai
Moderatore
   
Città: Macerata
Prov.: Macerata
Regione: Marche

1851 Messaggi
Micologia |
 Inserito il - 15 dicembre 2009 : 00:52:10 Inserito il - 15 dicembre 2009 : 00:52:10


|
L. hypoxanthum, foto da dia di qualche anno fà,
Immagine:

179,32 KB stesso luogo di crescita. |
 |
|
|
Ennio Carassai
Moderatore
   
Città: Macerata
Prov.: Macerata
Regione: Marche

1851 Messaggi
Micologia |
 Inserito il - 15 dicembre 2009 : 00:55:32 Inserito il - 15 dicembre 2009 : 00:55:32


|
questa è di venerdì scorso, a volte occorre "scavare" per trovarli.
Immagine:

201,34 KB |
 |
|
|
Ennio Carassai
Moderatore
   
Città: Macerata
Prov.: Macerata
Regione: Marche

1851 Messaggi
Micologia |
 Inserito il - 15 dicembre 2009 : 00:58:04 Inserito il - 15 dicembre 2009 : 00:58:04


|
esemplari grandi e in avanzato stato di vegetazione.
Immagine:

199,54 KB |
 |
|
|
Ennio Carassai
Moderatore
   
Città: Macerata
Prov.: Macerata
Regione: Marche

1851 Messaggi
Micologia |
 Inserito il - 15 dicembre 2009 : 01:01:16 Inserito il - 15 dicembre 2009 : 01:01:16


|
ultima foto,
di nuovo ciao a tutti,
Ennio.
Immagine:

199,69 KB |
 |
|
|
Ernesto Marra
Moderatore
   

Città: Lamezia Terme
Prov.: Catanzaro

2909 Messaggi
Micologia |
 Inserito il - 15 dicembre 2009 : 11:15:19 Inserito il - 15 dicembre 2009 : 11:15:19


|
Grazie Ennio
per averci proposto questa specie rara e davvero molto bella rappresentata da altrettanto belle foto. Vorrei cogliere l'occasione della tua disponibilità per approfondire.
Io trovo queste descrizioni:
Lyophyllum hypoxanthum
" ... cappello con rivestimento feltrato biancastro su fondo violaceo o lilla talvolta abbastanza deciso. Lamelle gialle vivaci. Gambo biancastro con riflessi lilla. Carne bianca, imbrunente lentamente. Sotto cipressi su suolo sabbioso".
e trovo ancora
Lyophyllum hypoxanthum var. occidentale
" ...cappello grigio rosato porpora molto pallido, poi brunastro pallido; lamelle giallo uovo, con taglio bruno; gambo biancastro; carne biancastra, virante al rosa, poi ingrigente o annerente in erbario; su dune perenni, in giardini in riva al mare sotto cipresso" .
Vedendo le sole foto avrei detto che il fungo da te proposto sembra avere più le caratteristiche macroscopiche della var. occidentalis, posso chiedere, a te che hai avuto il fungo in mano, cosa ti ha orientato invece ad escluderla?
Grazie 
P.s. In questo periodo invernale di scarsa fioritura fungina trovo che la proposizione di "quizmico" sia un ottimo input per l'approfondimento e questo si può anche notare dal numero di accessi che hanno le singole discussioni. Vorrei invitare pertanto a continuare, chi ne ha la possibilità di farlo, a proporne sempre di nuovi
ancora grazie ... |
Modificato da - Ernesto Marra in data 15 dicembre 2009 11:19:37 |
 |
|
|
giancarlo
Moderatore
   
Città: Perugia
Prov.: Perugia
Regione: Umbria

3025 Messaggi
Micologia |
 Inserito il - 15 dicembre 2009 : 12:04:28 Inserito il - 15 dicembre 2009 : 12:04:28


|
Ciao Ennio
complimenti!!!! veramete una specie rara io non l'ho mai vista .
Ho visto il quiz solamente ora ma non sarei comunque arrivato ne al genere ne alla specie.
un saluto
giancarlo |
 |
|
|
FOX
Moderatore
    

Città: BAGNO A RIPOLI
Regione: Toscana

21536 Messaggi
Tutti i Forum |
 Inserito il - 15 dicembre 2009 : 12:51:58 Inserito il - 15 dicembre 2009 : 12:51:58


|
Grazie Ennio,
complimenti...!
una specie ma vista prima d'ora...
i quiz a qualcosa servono, certamente questo non lo scorderemo mai..!
simo
Alto è il prezzo quando si sfida per vanità il mistero della Natura - I. Sheehan |
 |
|
|
Ennio Carassai
Moderatore
   
Città: Macerata
Prov.: Macerata
Regione: Marche

1851 Messaggi
Micologia |
 Inserito il - 15 dicembre 2009 : 16:11:51 Inserito il - 15 dicembre 2009 : 16:11:51


|
ciao a tutti,
rispondo in primis a Giget, ma vale per tutti.
Questa specie lo trovata per la 1^ volta nel novembre del 2000, sempre e solo nello stesso posto (un lungo viale di cuprexus sempervirens), tra il folto e spesso strato di aghi e altri residui vegetali, sempre profondamente interrata, tantè che molti esemplari non riescono ad "emergere" da questo sub-strato e si mummificano con il tempo.
La taglia è sempre massiccia (esemplari adulti) il cappello sempre sporco di terriccio ha una colorazione bianco sporco, bianco-grigiastra, coperto da una densa pruina bianca che si asporta difficilmente.
Gli esemplari fotografati, li ho puliti con un pennello per levare i residui terrosi e nel far questo è comparsa una leggera tonalità rosata.
La carne e biancastra e solo dopo mooolto tempo, tende ad ingrigire leggermente, anche in exiccata non diviene mai ne grigia, nerastra o tantomeno rossa.
Per una causa esterna, ho perso i dati micro delle raccolte precedenti, ma mi prometto di riprocurarmeli (freschi) da questi ultimi esemplari raccolti pochi giorni fà.
Condiderando le grandi dimensioni, il poco o nullo annerimento dei carpofori (lamelle comprese), l'habitat esclusivo (almeno per ora), seguendo la chiave del Genere Lyophyllum in Italia di Consiglio & Contu, pubblicata su Rivista di Micoogia dell'AMB (n.2-2002), sono arrivato a Lyophyllum hypoxantum come specie più attinente a tutte le mie raccolte.
A risentirci con piacere, anche per scambio di ulteriori pareri,
Ennio. |
 |
|
|
Ernesto Marra
Moderatore
   

Città: Lamezia Terme
Prov.: Catanzaro

2909 Messaggi
Micologia |
 Inserito il - 15 dicembre 2009 : 19:06:57 Inserito il - 15 dicembre 2009 : 19:06:57


|
Grazie,
aspettiamo, se possibile, di vedere anche i dati sulla microscopia così potremmo avere un quadro completo.
Ernesto |
 |
|
|
Ennio Carassai
Moderatore
   
Città: Macerata
Prov.: Macerata
Regione: Marche

1851 Messaggi
Micologia |
 Inserito il - 16 dicembre 2009 : 18:37:16 Inserito il - 16 dicembre 2009 : 18:37:16


|
C
Immagine:

151,32 KB iao a tutti,
scusate ma vado di fretta, posto solo alcune foto della micro di questo fungo, fatte oggi, con calma poi farò le cose più particolari.
1)spore x 1000 in acqua mis- 5 x 4 micron, per lo più subglobose qualcuna largamente ellissoidale, ialine.
Immagine:
172,78 KB |
 |
|
|
Ennio Carassai
Moderatore
   
Città: Macerata
Prov.: Macerata
Regione: Marche

1851 Messaggi
Micologia |
 Inserito il - 16 dicembre 2009 : 18:43:14 Inserito il - 16 dicembre 2009 : 18:43:14


|
2) spore x 1000 + legger
Immagine:

117,54 KB o zoom |
 |
|
|
Ennio Carassai
Moderatore
   
Città: Macerata
Prov.: Macerata
Regione: Marche

1851 Messaggi
Micologia |
 Inserito il - 16 dicembre 2009 : 18:45:47 Inserito il - 16 dicembre 2009 : 18:45:47


|
3) basidi, 28-30 x 8 micron, tetrasporici,
Immagine:

118,67 KB clavati, in rosso congo. |
 |
|
 Discussione Discussione  |
|
|
|
 Natura Mediterraneo Natura Mediterraneo |
© 2003-2024 Natura Mediterraneo |
 |
|
Leps.it | Herp.it | Lynkos.net
|

 Forum
|
Registrati
|
Msg attivi
|
Msg Recenti
|
Msg Pvt
|
Utenti
|
Galleria |
Map |
Forum
|
Registrati
|
Msg attivi
|
Msg Recenti
|
Msg Pvt
|
Utenti
|
Galleria |
Map |